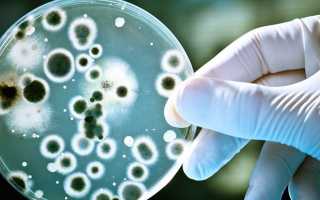
Профилактика амебиаза у детей и взрослых — способы и методы предотвращения заболевания

Амебиаз считается болезнью грязных рук. Заболевание вызвано проникновением в организм человека паразитического одноклеточного микроорганизма, сопровождается поражением толстого отдела кишечника с формированием язв на слизистой оболочке кишки. Чтобы избежать осложнений, требуется своевременно позаботиться о мерах профилактики.
Профилактические мероприятия амебной дизентерии
Возбудитель амебиаза (Amoebiasis) – дизентерийная или гистолитическая амеба (Entamoeba histolytica). Заражение этим простейшим происходит от другого человека, ранее переболевшего, который является носителем цист. Другие пути инфицирования – сточные воды, зараженная вода и продукты питания, бытовые и производственные предметы. Чтобы исключить амебиаз кишечника, профилактические мероприятия имеют 3 основных направления:
- Раннее выявление носителей и их изоляция.
- Диспансерное наблюдение за пациентом.
- Регулярное соблюдение правил гигиены.

Статьи по теме
- Причины аменореи у девушек – физиологические и психологические, методы лечения
- Лечение амебиаза – список противопаразитарных, пробиотиков и иммуномодуляторов
- Симптомы Амебиаза – как проявляется кишечный, кожный и внекишечный
При симптомах амебиаза пациенту необходима своевременная диагностика (обязательно сдать анализ кала) и пройти консервативное лечение (до 1–2 месяцев). В противном случае инфекционный процесс распространяется на другие внутренние органы, системы (печень, легкие и т. д.). Чтобы избежать проблем со здоровьем от болезнетворных бактерий, в домашних условиях необходимо придерживаться таких профилактических мероприятий:
- перед приготовлением пищи и после посещения туалета обязательно мыть руки;
- поддавать сырые продукты термической обработке (при температуре до 70 градусов);
- использовать питьевую бутилированную или кипяченую воду;
- для обработки сырых продуктов использовать отдельные кухонные приборы;
- не объединять сырые продукты с уже приготовленными блюдами;
- тщательно мыть сырые овощи и фрукты перед приготовлением;
- своевременно истреблять вредных насекомых в доме;
- не хранить приготовленные блюда при комнатной температуре более 2 часов;
- некоторое время избегать контакта с людьми, перенесшими амебиаз;
- не размораживать продукты питания при комнатной температуре.
Профилактика очень важна в эпидемиологическом отношении, поскольку препятствует распространению амебы среди населения.
Амебная дизентерия – опасное заболевание, поэтому придерживаться правил профилактики должен каждый человек независимо от возраста.
Особенно это касается представителей группы риска:
- пациенты с хроническими болезнями кишечника;
- жители населенных пунктов без канализации;
- работники очистных, канализационных сооружений;
- сотрудники пищевой промышленности;
- туристы, вернувшиеся из стран с тропическим и субтропическим климатом;
- работники торговли, общепита.
Мнение врачей:
Профилактика амебиаза важна как для детей, так и для взрослых. Врачи рекомендуют соблюдать гигиенические нормы, особенно при посещении общественных мест и путешествиях в страны с низким уровнем санитарии. Необходимо употреблять только чистую воду, овощи и фрукты, тщательно мойте руки перед едой и после посещения туалета. Для предотвращения заражения амебиазом рекомендуется обращаться к врачу при появлении симптомов заболевания, таких как понос, боли в животе, слабость. Своевременное обращение за медицинской помощью поможет предотвратить развитие заболевания и его осложнений.

Опыт других людей
Профилактика амебиаза играет важную роль как у детей, так и у взрослых. Люди отмечают, что основными способами предотвращения этого заболевания являются соблюдение гигиены рук, употребление только чистой воды и продуктов, тщательная термическая обработка пищи. Регулярное мытье фруктов и овощей перед употреблением также считается важным мероприятием. Вакцинация и прием антипаразитарных препаратов могут быть рекомендованы в определенных случаях. Следует помнить, что своевременное обращение к врачу при появлении симптомов заболевания также является ключевым в предотвращении его распространения.
Видео
https://youtube.com/watch?v=p-ZIXT-Aqhc
Внимание!
Информация, представленная в статье, носит ознакомительный характер. Материалы статьи не призывают к самостоятельному лечению. Только квалифицированный врач может поставить диагноз и дать рекомендации по лечению, исходя из индивидуальных особенностей конкретного пациента.
Статья обновлена: 07.09.2018

Частые вопросы
Как избавиться от амебы?
Лечение амебиаза Наиболее эффективные медикаменты для уничтожения возбудителей – метронидазол и тинидазол. Их назначают курсом от 3 до 8 дней. Лечение амебиаза включает дополнительные противомикробные препараты (интестопан, тетрациклины), лекарства для устранения диареи, вздутия живота, энтеросорбенты, витамины.
Какие методы диагностики используют при амебиазе?
Инфицирование E. histolytica часто протекает бессимптомно, но может вызывать кишечные симптомы, дизентерию или абсцессы печени. Диагностику амебной кишечной инфекции проводят с помощью тестов на фекальные антигены, молекулярных тестов на ДНК или при помощи микроскопии.
Как не заразиться дизентерийной амебой?
К общественной профилактике относятся: борьба с загрязнением почвы и воды фекалиями, обследование на цистоносительство людей, работающих на предприятиях общественного питания, лечение больных, уничтожение мух, санитарно-просветительская работа.
Какие симптомы при амебиазе?
Кишечный амебиаз Наиболее распространенная клиническая форма. Главный признак – нарастающие симптомы колита: обильный жидкий стул 4-6 раз в сутки, схваткообразные боли в животе. Затем характер стула меняется – его частота возрастает, а выделяемый объем падает, каловые массы пропадают, появляется прозрачная слизь.
Полезные советы
СОВЕТ №1
Пить только бутилированную или кипяченую воду, особенно в странах с низким уровнем санитарии, чтобы предотвратить заражение амебами через воду.
СОВЕТ №2
Соблюдать правила личной гигиены: тщательно мойте руки перед едой, после посещения туалета и контакта с грязью, чтобы избежать передачи инфекции.
СОВЕТ №3
Избегать употребления сырой или недостаточно прожаренной рыбы и мяса, так как они могут быть источником амебиаза.